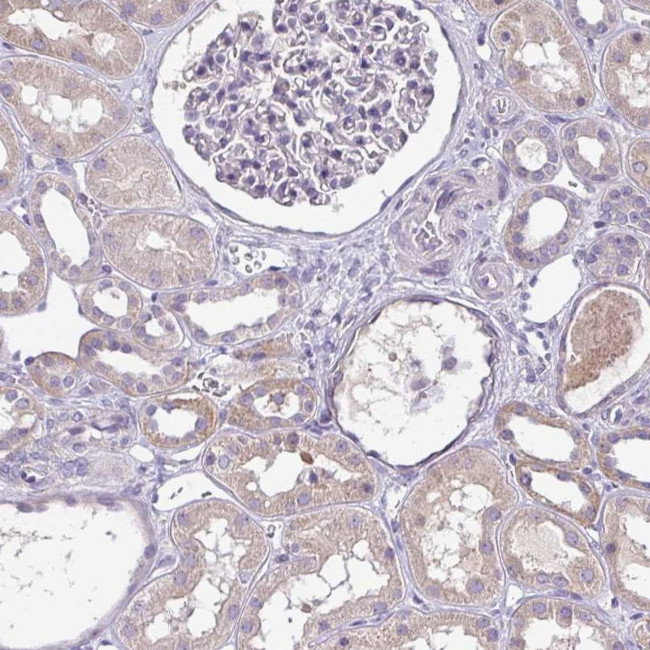
SFTPB Antibody in Immunohistochemistry (Paraffin) (IHC (P))

Search
Invitrogen
SFTPB Polyclonal Antibody
{{$productOrderCtrl.translations['antibody.pdp.commerceCard.promotion.promotions']}}
{{$productOrderCtrl.translations['antibody.pdp.commerceCard.promotion.viewpromo']}}
{{$productOrderCtrl.translations['antibody.pdp.commerceCard.promotion.promocode']}}: {{promo.promoCode}} {{promo.promoTitle}} {{promo.promoDescription}}. {{$productOrderCtrl.translations['antibody.pdp.commerceCard.promotion.learnmore']}}
产品信息
PA5-83246
种属反应
宿主/亚型
分类
类型
抗原
偶联物
形式
浓度
规格
纯化类型
保存液
内含物
保存条件
运输条件
RRID
产品详细信息
Immunogen sequence: AWTTSSLACA QGPEFWCQSL EQALQCRALG HCLQEVWGHV GADDLCQECE DIVHILNKMA KEAIFQDTMR KFLEQECNVL PLKLLMPQCN QVLDDYFP
Highest antigen sequence indentity to the following orthologs: Mouse - 74%, Rat - 77%.
靶标信息
Pulmonary surfactant is a complex mixture of phospholipids and proteins that is secreted from type II cells in alveoli and reduces the surface tension at the alveolar air-liquid interface, providing alveolar stability necessary for normal ventilation. Four distinct proteins isolated from pulmonary surfactant are termed surfactant proteins A, B, C, and D. SP-A (28-36kDa) and SP-D (43kDa) are collagenous carbohydrate-binding proteins, whereas SP-B (8-9kDa) and SP-C (4kDa) are non-collagenous hydrophobic proteins. SP-B is expressed in pulmonary adenocarcinomas with acinar, papillary, bronchioloalveolar, and solid growth patterns. Squamous cell and large cell carcinomas of the lung and nonpulmonary adenocarcinomas do not express SP-B. ProSP-B is glycosylated in the Golgi apparatus and undergoes carboxy- and amino-terminal proteolysis by a cathepsin D-like protease.
仅用于科研。不用于诊断过程。未经明确授权不得转售。
篇参考文献 (0)
生物信息学
蛋白别名: 18 kDa pulmonary-surfactant protein; 6 kDa protein; P SFTB3; Pulmonary surfactant-associated protein B; Pulmonary surfactant-associated proteolipid SPL(Phe); SFPB; SP-B; sufactant apoprotein 18 precursor; unnamed protein product
基因别名: PSP-B; SFTB3; SFTP3; SFTPB; SMDP1; SP-B
UniProt ID: (Human) P07988
Entrez Gene ID: (Human) 6439